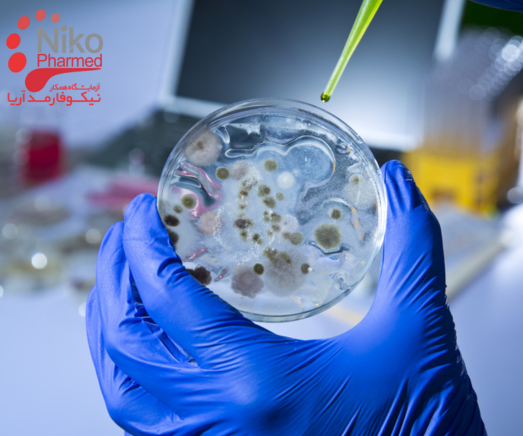
تست میکروبی
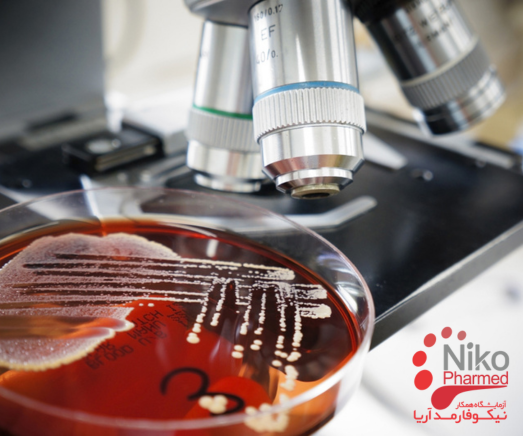
اهمیت انجام تست میکروبی برای تجهیزات پزشکی
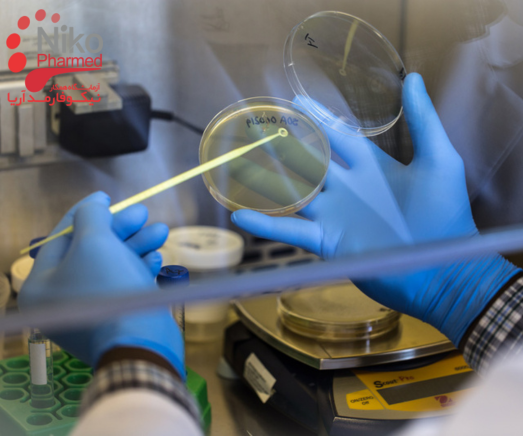
آزمون میکروبی

تست میکروبی چیست؟
تست میکروبی، مجموعهای از آزمایشهای علمی و دقیق است که با هدف شناسایی، شمارش و ارزیابی میکروارگانیسمها در یک ماده یا محیط خاص در آزمایشگاه همکار نیکوفارمد انجام میشود. این تستها که در حوزههای مختلفی از جمله پزشکی، داروسازی، کشاورزی، صنایع غذایی و کنترل کیفیت آب کاربرد دارند، نقشی حیاتی در ارتقای سلامت انسان، تضمین کیفیت محصولات و پیشرفت دانش بشری ایفا میکنند.
اهداف اساسی تست میکروبی
- حفظ سلامت انسان: شناسایی و حذف میکروارگانیسمهای مضر از طریق تستهای میکروبی، در پیشگیری از بیماریهای عفونی و حفظ سلامت انسان و حیوان نقشی کلیدی دارد.
- کنترل کیفیت محصولات: در صنایع مختلف، از جمله داروسازی و غذایی، این تستها برای اطمینان از انطباق محصولات با استانداردهای میکروبی و بهداشتی انجام میشوند.
- ارزیابی کارایی ضدعفونی: تست میکروبی میزان اثربخشی روشهای مختلف ضدعفونی و استریلیزاسیون را در از بین بردن میکروارگانیسمها بررسی میکند و ضامن سلامت و بهداشت محیط است.
- تحقیقات علمی: دانشمندان از این تستها برای مطالعه رفتار و خصوصیات میکروارگانیسمها، توسعه داروها و روشهای درمانی جدید و درک عمیقتر بیماریها استفاده میکنند و به ارتقای دانش بشری کمک میکنند.
انواع تست های میکروبی
- شمارش میکروبی: تعیین تعداد میکروارگانیسم ها در نمونه ها
- بار میکروبی دارو: شناسایی نوع میکروارگانیسم آلوده کننده دارو
- بررسی فعالیت ضد میکروبی: سنجش کارایی ضدعفونی کننده ها، شوینده ها و ضدعفونی کننده ها در از بین بردن میکروارگانیسم ها
- تست انتشار دیسک: تعیین حساسیت میکروارگانیسم ها به آنتی بیوتیک ها
- MIC/MBC: تعیین حداقل غلظت آنتی بیوتیک برای مهار یا کشتن میکروارگانیسم
- تست مایکوپلاسما: تشخیص مایکوپلاسما در نمونه های مختلف
- تست استریلیتی: اطمینان از عاری بودن دارو و تجهیزات پزشکی از میکروارگانیسم
- تب زایی اندوتوکسین: تشخیص اندوتوکسین در دارو و تجهیزات پزشکی و بررسی احتمال ایجاد تب
اهمیت انجام تست میکروبی برای تجهیزات پزشکی
تجهیزات پزشکی برای تشخیص، درمان یا پیشگیری از بیماری در انسان ها استفاده می شوند. استریل بودن و عاری بودن این تجهیزات از هرگونه میکروارگانیسم مضر برای حفظ سلامت بیماران و جلوگیری از انتقال عفونت ضروری است.
انجام تست های میکروبی برای تجهیزات پزشکی به دلایل زیر اهمیت دارد:
1. اطمینان از استریل بودن:
تست های میکروبی مانند تست استریلیتی به طور قطعی نشان می دهند که آیا تجهیزات پزشکی از میکروارگانیسم، ویروس، قارچ و باکتری عاری هستند یا خیر. این امر برای جلوگیری از ایجاد عفونت در بیمارانی که از این تجهیزات استفاده می کنند حیاتی است.
2. کاهش خطر عفونت های بیمارستانی:
عفونت های بیمارستانی یکی از مشکلات اصلی در زمینه بهداشت و درمان به شمار می روند. تجهیزات پزشکی غیر استریل می توانند عامل انتقال این عفونت ها باشند. انجام تست های میکروبی به طور منظم می تواند به کاهش خطر ایجاد این عفونت ها کمک کند.
3. افزایش طول عمر تجهیزات پزشکی:
میکروارگانیسم ها می توانند به تجهیزات پزشکی آسیب برسانند و طول عمر آنها را کاهش دهند. انجام تست های میکروبی به طور منظم می تواند به شناسایی و از بین بردن میکروارگانیسم ها قبل از ایجاد آسیب به تجهیزات کمک کند.
4. محافظت از سلامت کارکنان مراقبت های بهداشتی:
کارکنان مراقبت های بهداشتی در تماس مستقیم با تجهیزات پزشکی هستند و در معرض خطر عفونت ناشی از این تجهیزات قرار دارند. انجام تست های میکروبی به طور منظم می تواند به محافظت از سلامت این کارکنان کمک کند.
5. جلوگیری از مسئولیت های قانونی:
اگر تجهیزات پزشکی غیر استریل باعث ایجاد عفونت در بیمار شود، ممکن است تولید کننده یا مرکز درمانی مسئول شناخته شود و مورد پیگرد قانونی قرار گیرد. انجام تست های میکروبی به طور منظم می تواند به کاهش خطر ایجاد چنین مسئولیت هایی کمک کند.
در مجموع، انجام تست های میکروبی برای تجهیزات پزشکی از اهمیت بسیاری برخوردار است و می تواند به نفع بیماران، کارکنان مراقبت های بهداشتی و تولید کنندگان تجهیزات پزشکی باشد.
تست بار زیستی
آزمایش بار زیستی به منظور مطابقت با مقررات FDA در مورد وسایل پزشکی مورد نیاز است. آزمایش بار زیستی تعداد میکروارگانیسمهای زنده مانند باکتریها، مخمرها و کپکها را که قبل از عقیمسازی روی دستگاه پزشکی قرار دارند، شناسایی میکند. آزمایش بار زیستی لازم است و قبل از آزمایشات استریلیزاسیون انجام می شود.
تست و اعتبارسنجی عقیمی
آزمایش عقیم سازی و اعتبارسنجی مراحل لازم برای همه دستگاه های پزشکی است. انواع مختلفی از تستهای استریلی مانند تست انتقال مستقیم، استریلیت فلاش محصول، تستهای استریلی USP و غیره وجود دارد. در بسیاری از مواقع، میکروارگانیسمهای زنده ممکن است روی دستگاه پزشکی باقی بمانند، جایی که یک محیط ایدهآل برای رشد و شکوفایی وجود دارد. انجام این آزمایشات برای جلوگیری از شیوع بیماری های عفونی بسیار مهم است.
پایش محیط زیست
در حالی که پایش محیطی لزوماً مستقیماً بر روی تجهیزات پزشکی انجام نمی شود، بخش بزرگی از حذف عوامل آلودگی است. بدون یک اتاق تمیز مناسب، دستگاه ها بیشتر در معرض آلودگی هوا و در نتیجه گسترش بیماری و بیماری هستند. پایش محیطی به حذف این آلایندههایی که توسط افراد، فرآیندها و تأسیسات تولید میشوند، کمک میکند. اینها باید به طور مداوم از هوا حذف شوند و این کار از طریق نمونه برداری از هوا، نمونه برداری از سطح، کنترل رطوبت و دما، شناسایی میکروارگانیسم ها و همچنین روش های دیگر انجام می شود.
ایمنی تجهیزات پزشکی
ایمنی تجهیزات پزشکی برای جلوگیری از شیوع بیماری های عفونی و بیماری بسیار مهم است. FDA واکنش های نامطلوب و سایر مشکلات دستگاه های پزشکی را نظارت و گزارش می کند و سپس به متخصصان پزشکی و همچنین مردم هشدار می دهد. آزمایش صحیح دستگاه های پزشکی برای متخصصان بهداشت و کسانی که از آنها استفاده می کنند حیاتی است.
آزمایش میکروبیولوژیکی برای ارزیابی ویژگیهای میکروبیولوژیکی دستگاههای نهایی، فرآیند ساخت و محیط ساخت میتواند به حذف یا به حداقل رساندن خطر آلودگی میکروبی و در نتیجه خطر ابتلا به عفونت برای بیماران، کاربران یا اشخاص ثالث کمک کند.
STC دامنه جامعی از آزمایش میکروبیولوژیکی را برای کمک به سازندگان تجهیزات پزشکی در برآوردن الزامات ایمنی میکروبیولوژیکی و استریلیزاسیون برای تأیید نظارتی ارائه می دهد.

برای کسب اطلاعات بیشتر و دریافت خدمات با ما تماس بگیرید.
قابلیت های تست
تست بار زیستی
تعیین اندوتوکسین
تست عقیمی
تست یکپارچگی بسته
عمر مفید / اعتبار سنجی چرخه عمر
شناسایی میکروبی
تست جامع
چالش ضد میکروبی
اعتبار سنجی پاکسازی
ارزیابی های میکروبی سفارشی
تست محدودیت های میکروبیولوژیکی
نمونه برداری و آزمایش آب برای استریلیت و ایمنی میکروبیولوژیکی
تمیز کردن دستگاههای پزشکی گامی حیاتی برای ارزیابی زیست سازگاری و کنترل بار میکروبیولوژیکی برای استریلسازی است که دقیقاً مطابق با الزامات ISO 10993-1 است. ایمنی بیمار نه تنها به مواد خاصی که مورد استفاده قرار می گیرند مربوط می شود، بلکه به درک آلاینده ها یا باقیمانده هایی که می توانند در طی فرآیندهای تولید و جابجایی وارد یا مشاهده شوند نیز مربوط می شود.
روشها و کارهای تمیز کردن مورد استفاده باید ارزیابی شوند تا اطمینان کامل حاصل شود که تأثیر منفی بر زیست سازگاری یا عملکرد عملکرد دستگاه ندارند. علاوه بر این، اعتبار سنجی تمیز کردن تضمین می کند که فرآیند تمیز کردن سطوح کافی از آلاینده ها را بدون وارد کردن آلاینده های جدید حذف می کند. ارزیابی تمیزی دستگاهها میتواند شامل آزمایش خلوص آب مورد استفاده در فرآیندهای تولید به صورت فصلی یا ماهانه، تأیید حذف باقیماندههای مواد تمیزکننده و کاهش خطرات زیستمحیطی باشد. حوزههای دیگر دارای ارزیابی خطر مواد مورد استفاده در فرآیند تمیز کردن و شناسایی آلایندههای بالقوه در طول فرآیند تولید و همچنین حصول اطمینان از اینکه سطح بار زیستی قبل از استریلسازی به اندازه کافی کم است.
ارزیابی تمیزی دستگاه های مخصوص به فرآیندهای تولید محدود نمی شود. دستگاه های پزشکی قابل استفاده ی مجدد بین بیماران تحت تمیز کردن و همچنین ضد عفونی کردن، یا استریل کردن، پردازش مجدد قرار می گیرند. این دستورالعملهای بازفرآوری برای استفاده (IFU) باید برای جلوگیری از هرگونه آلودگی بین بیماران در محیطهای مراقبتهای بهداشتی معتبر باشد.
به طور کلی، این مسئولیت سازنده است که دستگاه های تمیز را در اختیار کاربر قرار دهد. هدف از اعتبار سنجی تمیز کردن، تعیین کردن اثربخشی فرآیندهای تمیز کردن برای حذف آلایندههای فیزیکی و شیمیایی و میکروبی یا باقیماندههای زیر یک سطح تعریف شده است. این را می توان با مراحل تمیز کردن فرآیند که برای حذف هر گونه آلودگی از مرحله قبل طراحی شده است، و تمیز کردن نهایی قبل از توزیع قطعات انجام داد. ISO 19227 راهنمایی است که اغلب برای ارزیابی تمیزی ایمپلنت های ارتوپدی استفاده می شود و شامل روش های ذکر شده در زیر است. روش های مرتبط اضافی نیز تشریح شده است.
شراکت نیکوفارمد به شرکت شما امکان می دهد تا ریسک را کاهش دهد و بداند که ما سخت تلاش می کنیم تا محصول ایمن شما را به سرعت به بازار عرضه کنیم. برای اطلاعات بیشتر در مورد خدمات تجزیه و تحلیل میکروبیولوژیکی ما یا درخواست قیمت، همین امروز با ما تماس بگیرید.
مقالات بیشتر:
برای اطمینان از این امر، آزمایش های معمول دستگاه های پزشکی و دارویی لازم است
روند تولید همچنان تحت کنترل است. روش تست میکروبیولوژیکی
بستگی به نوع محصول یا جزء و کنترل کیفیت منحصر به فرد دارد
استانداردهایی که باید رعایت شوند.
هنگامی که به دنبال خدمات مشاوره میکروبیولوژی و استریلیزاسیون هستید، مهم است
اطمینان حاصل شود که تیم تجربه خاصی در زمینه دارویی و پزشکی دارد
صنایع دستگاه و پایبند به کمیته استانداردهای ملی میکروبیولوژی است
و عقیم سازی

برای کسب اطلاعات بیشتر و دریافت خدمات با ما تماس بگیرید.
اعتبارسنجی و آزمایش بار زیستی
◾ اعتبارسنجی زیست بار تضمین می کند که روش آزمایش بار زیستی موثر است
در بازیابی میکروارگانیسم های موجود در دستگاه.
◾ آزمایش بار زیستی تعیین می کند که چند میکروب روی غیر استریل وجود دارد
دستگاه پزشکی، جزء یا ظرف، و بر روی یک محصول انجام می شود
که نیاز به کنترل / نظارت بر شمارش بار زیستی دارد.
اعتبارسنجی و آزمایش عقیمی
◾ اعتبار سنجی روش تست عقیمی تضمین می کند که میکروارگانیسم ها می توانند باشند
در حضور محصول تحت شرایط آزمایش بازیابی می شود.
◾ تست عقیمی برای تعیین وجود یا عدم وجود زنده استفاده می شود
میکروارگانیسمهای موجود در دستگاههای پزشکی (یا بخشهایی از آن) و استفاده میشود
تایید مناسب بودن حداقل دوز عقیم سازی در دستیابی
سطح تضمین عقیمی مورد نیاز (SAL).
◾ تست عقیمی در فارماکوپه ها مشخص شده است و می باشد
بر روی محصول به دنبال فرآیند آسپتیک یا قرار گرفتن در معرض
یک فرآیند عقیم سازی
ممیزی دوز عقیم سازی، اثبات و تنظیم
◾ اثبات دوز عقیم سازی و مطالعات تنظیم حداقل را تایید می کند
دوز تابش مورد نیاز برای دستیابی به سطح تضمین عقیمی مورد نیاز (SAL).
◾ ممیزی دوز عقیم سازی ادامه مناسب بودن حداقل را تایید می کند
دوز تابش برای رسیدن به سطح تضمین عقیمی مورد نیاز (SAL).
پایش محیط زیست
◾ برای آزمایش آلاینده های سطحی و هوا در داروسازی استفاده می شود
اتاق های تمیز و همچنین سایر محیط های کنترل شده
◾ پایش سطحی اطمینان حاصل می کند که جمعیت میکروبی در سطح قابل قبولی هستند
با استفاده از تکنیک های تماس، سواب و شستشو.
◾ پایش هوا شامل ارزیابی غیر قابل دوام (غیر زنده) و قابل دوام است
آلودگی هوا (زنده) که پتانسیل ته نشین شدن را دارد و بنابراین
محصولات را آلوده کند
شرایط کار دستگاه های پزشکی الکترونیکی چقدر می تواند سخت باشد؟
تجهیزات پزشکی الکترونیکی؛ می دانیم که آنها به آب، دما و فشار حساس هستند. به عنوان مثال هنگام استفاده از تلفن همراه خود از آن محافظت می کنیم تا مایعی روی آن نریزد. زیرا می دانیم که اگر مایع به درایوهای الکترونیکی برسد، دستگاه از کار می افتد. یا زمانی که هوا گرم است باید گوشی خود را در جای خنک تری نگهداری کنیم تا آسیب نبیند. برعکس وقتی سرد است آن را به محیط گرمتری می بریم. یک مقدار رطوبت و دمای مناسب برای عملکرد سالم سیستم های الکترونیکی مورد نیاز است. بالاتر یا کمتر از این مقادیر، قطعات الکترونیکی به راحتی ممکن است از کار بیفتند. بنابراین، شرایط کار دستگاه های پزشکی الکترونیکی چقدر می تواند چالش برانگیز باشد؟
دستگاهی را در نظر بگیرید؛ برای استریل شدن قبل از هر عمل جراحی باید به مدت 1 ساعت در معرض بخار فشار 135 درجه سانتیگراد قرار گیرد، سطوح سخت استخوانی در حین جراحی شکل داده شود و با آب های شیمیایی شسته شود تا خون و بافت های استخوانی خشک شده روی آن از بین برود. بعد از جراحی نام این دستگاه های پزشکی الکترونیکی سیستم های حرکتی جراحی است که در ارتوپدی و تروماتولوژی استفاده می شود.
مقالات بیشتر:
تشخیص سودوموناس در محصولات پزشکی
فاکتور دما
تمام سیستم های موتور جراحی باید دمای اتوکلاو 135 درجه سانتی گراد را تحمل کنند. پس از این فرآیند، هندپیس ها باید منتظر بمانند تا به دمای اتاق برسند. با این حال، به دلیل افزایش هزینه ها، تعداد محدودی از سیستم های حرکتی جراحی در بیمارستان ها با توجه به تعداد عمل ها وجود دارد. به همین دلیل، یک دستگاه واحد می تواند وارد عملیات متوالی شود. این تقصیر کاربر دستگاه نیست، بلکه یک تعهد است.
در برخی موارد پرسنل بیمارستان به دلیل اینکه می خواهند دستگاه به سرعت خنک شود، سعی می کنند با اسپری خنک کننده دستگاه را خنک کنند. اسپری خنک کننده به سرعت سطح بیرونی دستگاه را خنک می کند و هندپیس قابل گرفتن می شود. اما دمای داخلی دستگاه همچنان بالای 100 درجه است. هنگامی که به این روش کار می کند، ممکن است دستگاه آسیب ببیند.
به همین دلیل باید از قطعات مقاوم در برابر دمای بالا در درایور الکترونیکی موتور جراحی استفاده شود.
تماس مایع
سیستم های حرکتی جراحی با پاشش خون و بافت روی سطح باید پس از جراحی شسته شوند. اگر خون و بافت روی دستگاه ها در اثر انتظار طولانی بعد از عمل خشک شود، تمیز کردن آن بسیار مشکل می شود. به این دلایل، سیستم های موتور جراحی باید حداکثر تا 30 دقیقه پس از عمل تمیز شوند.
هر سیستم موتور جراحی با توجه به درجه حفاظت از مایع (IP) دستورالعمل های شستشوی خاصی دارد.
گاهی اوقات، پس از انجام عمل های بیماران مبتلا به بیماری های عفونی، کارکنان بیمارستان که مسئول فرآیند شستشو هستند، ممکن است از دستورالعمل های شستشو خارج شوند تا از تمیز شدن کامل دستگاه اطمینان حاصل کنند.
به عنوان مثال، دستگاهی با درجه حفاظت مایع IPX4 (فقط محافظت در برابر پاشش پاشش) را می توان در زیر شیر آب غلیظ شست، یا دستگاه با درجه IPX6 (که می تواند زیر شیر آب یا در ماشین اتوماتیک شسته شود) را می توان با غوطه ور کردن تمیز کرد.
سازنده هنگام طراحی یک دستگاه باید تمام خطرات را در نظر بگیرد. به همین دلیل در تعیین شرایط استریلیزاسیون و شستشو در نظر گرفته می شود که بیماری عفونی به پرسنل بیمارستان و سایر بیماران منتقل نشود و تمامی مراحل با آزمایشات ثابت می شود. رعایت دستورالعمل های استفاده و شستشو برای کارکنان بیمارستان برای محافظت از خود، بیمار بعدی و دستگاه بسیار مهم است. سیستم های موتور جراحی در صورت شستن خارج از دستورالعمل های شستشوی سازنده آسیب می بینند.
استفاده مجدد از تیزهای کسل کننده و مواد مصرفی سوراخ کننده
سیستم های موتور جراحی با تیغه های اره جراحی یکبار مصرف و مته ها استفاده می شود. صرفه جویی هایی که با در نظر گرفتن بودجه بیمارستان یا شرکت انجام می شود در درجه اول به بیمار و سپس دستگاه آسیب می زند.
در جراحی تعویض زانو که با تیغه اره جراحی بلانت انجام می شود، با طولانی شدن فرآیند برش، سطح استخوان بیمار آسیب می بیند. در عین حال، دستگاه پرقدرت زمانی که با تیغه و استخوان ارهای کند مواجه میشود، در معرض نیروی اضافی قرار میگیرد. این امر منجر به کاهش عمر مکانیکی دستگاه می شود.
ارزیابی
ارتباط موثر بین سازنده و بیمارستان برای آشکار شدن طول عمر واقعی دستگاه ها مورد نیاز است. این مسئولیت بیمارستان است که تعداد دستگاه ها را با توجه به تعداد عملیات تعیین کند و سازنده اقدامات احتیاطی را در برابر این شرایط سخت انجام دهد.
سیستم های موتور جراحی کمی بیشتر از توجه به سایر دستگاه های الکترونیکی نیاز دارند، زیرا دستگاه هایی با هزینه های بالا و شرایط کاری دشوار هستند.
آزمون تعیین بار میکروبی|بار میکروبی|پایش میکروبی|پلیت های آماده میکروبی